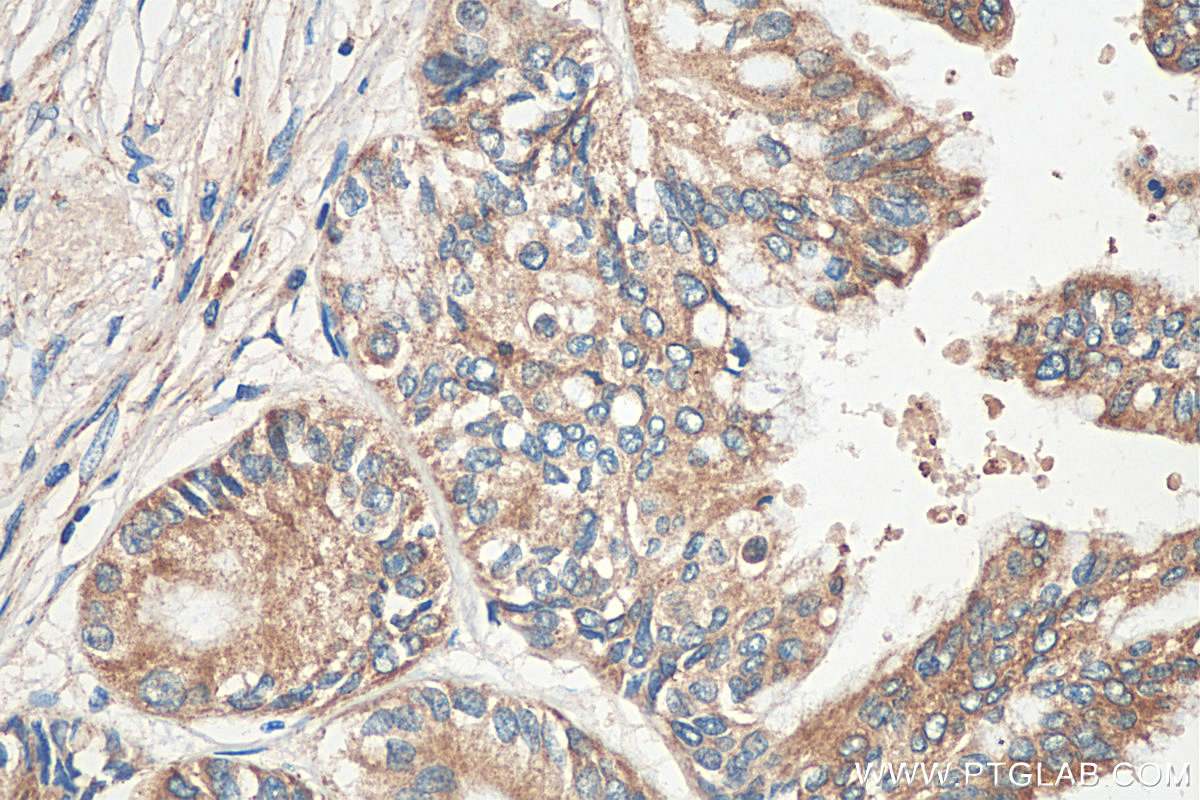

验证数据展示
经过测试的应用
| Positive WB detected in | A549 cells, LNCaP cells, PC-3 cells |
| Positive IP detected in | A549 cells |
| Positive IHC detected in | human pancreas cancer tissue Note: suggested antigen retrieval with TE buffer pH 9.0; (*) Alternatively, antigen retrieval may be performed with citrate buffer pH 6.0 |
| Positive FC (Intra) detected in | A549 cells |
推荐稀释比
| 应用 | 推荐稀释比 |
|---|---|
| Western Blot (WB) | WB : 1:1000-1:6000 |
| Immunoprecipitation (IP) | IP : 0.5-4.0 ug for 1.0-3.0 mg of total protein lysate |
| Immunohistochemistry (IHC) | IHC : 1:50-1:500 |
| Flow Cytometry (FC) (INTRA) | FC (INTRA) : 0.40 ug per 10^6 cells in a 100 µl suspension |
| It is recommended that this reagent should be titrated in each testing system to obtain optimal results. | |
| Sample-dependent, Check data in validation data gallery. | |
产品信息
27528-1-AP targets IRE1/ERN1 in WB, IHC, IF, FC (Intra), IP, CoIP, ELISA applications and shows reactivity with human samples.
| 经测试应用 | WB, IHC, FC (Intra), IP, ELISA Application Description |
| 文献引用应用 | WB, IHC, IF, CoIP |
| 经测试反应性 | human |
| 文献引用反应性 | human, rat, bovine |
| 免疫原 |
CatNo: Ag25580 Product name: Recombinant human IRE1; ERN1 protein Source: e coli.-derived, PGEX-4T Tag: GST Domain: 368-565 aa of BC130405 Sequence: PLSASTKMLERFPNNLPKHRENVIPADSEKKSFEEVINLVDQTSENAPTTVSRDVEEKPAHAPARPEAPVDSMLKDMATIILSTFLLIGWVAFIITYPLSMHQQQQLQHQQFQKELEKIQLLQQQQQQLPFHPPGDTAQDGELLDTSGPYSESSGTSSPSTSPRASNHSLCSGSSASKAGSSPSLEQDDGDEETSVVI 种属同源性预测 |
| 宿主/亚型 | Rabbit / IgG |
| 抗体类别 | Polyclonal |
| 产品类型 | Antibody |
| 全称 | endoplasmic reticulum to nucleus signaling 1 |
| 别名 | ERN1, IRE1; ERN1, Endoplasmic reticulum-to-nucleus signaling 1, Endoribonuclease, ERN 1 |
| 计算分子量 | 977 aa, 110 kDa |
| 观测分子量 | 130 kDa |
| GenBank蛋白编号 | BC130405 |
| 基因名称 | IRE1 |
| Gene ID (NCBI) | 2081 |
| RRID | AB_2880899 |
| 偶联类型 | Unconjugated |
| 形式 | Liquid |
| 纯化方式 | Antigen affinity purification |
| UNIPROT ID | O75460 |
| 储存缓冲液 | PBS with 0.02% sodium azide and 50% glycerol, pH 7.3. |
| 储存条件 | Store at -20°C. Stable for one year after shipment. Aliquoting is unnecessary for -20oC storage. |
背景介绍
Inositol-requiring enzyme 1 (IRE1) is an ER transmembrane sensor that activates the UPR to maintain the ER and cellular function. Although mammalian IRE1 promotes cell survival, it can initiate apoptosis via decay of antiapoptotic miRNAs. IRE1 contains a ribonuclease domain in its cytoplasmic region which initiates splicing reaction by direct cleavage of XBP1 mRNA at the two stem loop structures. IRE1 plays instrumental protumoral roles in several cancers, and high IRE1 activity has been associated with poorer prognoses. (PMID: 23880584, PMID: 32861679, PMID: 31875595)
实验方案
| Product Specific Protocols | |
|---|---|
| FC protocol for IRE1/ERN1 antibody 27528-1-AP | Download protocol |
| IHC protocol for IRE1/ERN1 antibody 27528-1-AP | Download protocol |
| IP protocol for IRE1/ERN1 antibody 27528-1-AP | Download protocol |
| WB protocol for IRE1/ERN1 antibody 27528-1-AP | Download protocol |
| Standard Protocols | |
|---|---|
| Click here to view our Standard Protocols |
发表文章
| Species | Application | Title |
|---|---|---|
Cell Human T-bet Governs Innate and Innate-like Adaptive IFN-γ Immunity against Mycobacteria. | ||
Cell Stem Cell Amino acid catabolism regulates hematopoietic stem cell proteostasis via a GCN2-eIF2α axis. | ||
Redox Biol FUT2-dependent fucosylation of HYOU1 protects intestinal stem cells against inflammatory injury by regulating unfolded protein response | ||
Genome Biol Balanced mitochondrial and cytosolic translatomes underlie the biogenesis of human respiratory complexes | ||
MedComm (2020) HBV Precore G1896A Mutation Promotes Malignancy of Hepatocellular Carcinoma by Activating Endoplasmic Reticulum Stress to Enhance Aerobic Glycolysis | ||
J Hazard Mater Endoplasmic reticulum stress manipulates autophagic response that antagonizes polybrominated diphenyl ethers quinone induced cytotoxicity in microglial BV2 cells. |